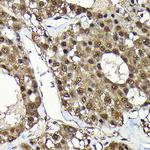
ADRM1 Antibody in Immunohistochemistry (Paraffin) (IHC (P))

Search
Invitrogen
ADRM1 Polyclonal Antibody
{{$productOrderCtrl.translations['antibody.pdp.commerceCard.promotion.promotions']}}
{{$productOrderCtrl.translations['antibody.pdp.commerceCard.promotion.viewpromo']}}
{{$productOrderCtrl.translations['antibody.pdp.commerceCard.promotion.promocode']}}: {{promo.promoCode}} {{promo.promoTitle}} {{promo.promoDescription}}. {{$productOrderCtrl.translations['antibody.pdp.commerceCard.promotion.learnmore']}}

Please note: We are reviewing Western blot images included in the antibody testing data in our catalog, including those provided by third parties. Unless expressly labeled or annotated as “raw-unedited”, Western blot images included in the antibody testing data in our catalog may have been edited, optimized or otherwise adjusted for presentation.
产品信息
PA5-92231
种属反应
宿主/亚型
分类
类型
抗原
偶联物
形式
浓度
规格
纯化类型
保存液
内含物
保存条件
运输条件
RRID
产品详细信息
Immunogen sequence: WMQEPKTDQD EEHCRKVNEY LNNPPMPGAL GASGSSGHEL SALGGEGGLQ SLLGNMSHSQ LMQLIGPAGL GGLGGLGALT GPGLASLLGS SGPPGSSSSS SSRSQSAAVT PSSTTSSTRA TPAPSAPAAA SATSPSPAPS SGNGASTAAS PTQPIQLSDL QSILATMNVP AGPAGGQQVD LASVLTPEIM APILANADVQ ERLLPYLPSG ESLPQTADEI QNTLTSPQFQ QALGMFSAAL ASGQLGPLMC QFGLPAEAVE AANKGDVEAF AKAMQNNAKP EQKEGDTKDK KDEEEDMSLD; Positive Samples: HeLa, LO2, 293T, MCF-7, SW480; Cellular Location: Cytoplasm, Nucleus
靶标信息
The protein encoded by this gene is an integral plasma membrane protein which promotes cell adhesion. The encoded protein is thought to undergo O-linked glycosylation. Expression of this gene has been shown to be induced by gamma interferon in some cancer cells. Two transcript variants encoding the same protein have been found for this gene.
仅用于科研。不用于诊断过程。未经明确授权不得转售。
篇参考文献 (0)
生物信息学
蛋白别名: 110 kDa cell membrane glycoprotein; Adhesion-regulating molecule 1; ARM-1; cell membrane glycoprotein, 110000M(r) (surface antigen); glycoprotein 110; Gp110; MGC29536; Proteasomal ubiquitin receptor ADRM1; Rpn13 homolog
基因别名: 1110063P18Rik; 2510006J17Rik; AA408205; Adrm1; ARM-1; Arm1; AU043535; Gp110; Rpn13
UniProt ID: (Rat) Q9JMB5, (Mouse) Q9JKV1
Entrez Gene ID: (Rat) 65138, (Mouse) 56436




